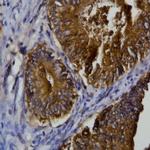
PLAC1 Antibody in Immunohistochemistry (Paraffin) (IHC (P))
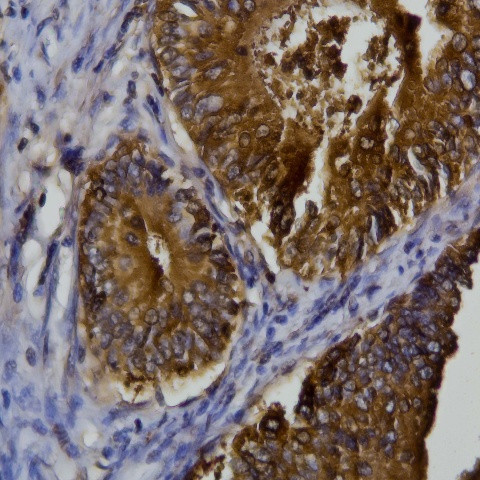
PLAC1 Antibody in Immunohistochemistry (Paraffin) (IHC (P))

Search
AbboMax
PLAC1 Polyclonal Antibody
{{$productOrderCtrl.translations['antibody.pdp.commerceCard.promotion.promotions']}}
{{$productOrderCtrl.translations['antibody.pdp.commerceCard.promotion.viewpromo']}}
{{$productOrderCtrl.translations['antibody.pdp.commerceCard.promotion.promocode']}}: {{promo.promoCode}} {{promo.promoTitle}} {{promo.promoDescription}}. {{$productOrderCtrl.translations['antibody.pdp.commerceCard.promotion.learnmore']}}
图: 1 / 2
PLAC1 Antibody (620-390) in IHC (P)

产品信息
620-390
种属反应
宿主/亚型
分类
类型
抗原
偶联物
形式
浓度
纯化类型
保存液
内含物
保存条件
运输条件
产品详细信息
Positive control: HepG2
Cellular location: membrane.
靶标信息
PLAC1 was initially identified as a protein expressed specifically in the placenta and other cells derived from the trophoblast lineage during embryonic development, but has also been found to be expressed ectopically in a wide range of human malignancies, particularly breast cancers. PLAC1 is a membrane-associated protein that is thought to serve a receptor-like function modulating cell-cell or ligand receptor interactions unique to the maternal-placental interface. Decreased expression of PLAC1 is associated with decreased expression of cyclin D1 and reduced expression of AKT kinase, which, combined with the fact that PLAC1 is expressed on the surface of cancer cells, suggests that PLAC1 may be an effective candidate for immunotherapeutic treatments of cancer.
仅用于科研。不用于诊断过程。未经明确授权不得转售。
篇参考文献 (0)
生物信息学
蛋白别名: cancer/testis antigen 92; placenta specific 1; Placenta-specific protein 1; unnamed protein product
基因别名: CT92; OOSP2B; OOSP2L; PLAC1
UniProt ID: (Human) Q9HBJ0
Entrez Gene ID: (Human) 10761